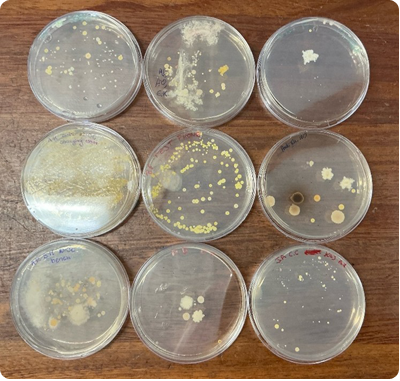
Biology4

Agricultural Science
Transition Year Agricultural Science is a rotation subject that gives students an engaging introduction to Irish agriculture over a 6–8 week block. The course covers a range of practical and relevant topics such as farm health and safety, dairy and sheep farming, butter making, grass/weed varieties, silage testing, pig farming, and career opportunities in the agricultural industry. Through hands-on activities and real-world examples, students gain an understanding of how modern Irish farming operates and its importance to the national economy. TY Ag Science also offers a valuable insight into what’s involved in Leaving Certificate Agricultural Science, encouraging interest among students from both farming and non-farming backgrounds.


Applied Maths
Transition Year Applied Maths in Scoil Pól focuses on applying mathematical concepts to areas such as physics, engineering, construction and everyday situations, helping students see the connection between maths and the world around them. Through problem-solving activities, projects, and teamwork, students develop logical thinking and analytical skills. The aim is to make maths more engaging, build confidence, and prepare students for senior cycle subjects like Applied Maths, Physics, and Maths.


Visual Art Module Purpose
The Visual Art curriculum is designed to foster creativity, critical thinking and visual literacy in students. Through a combination of hands-on experiences and theoretical exploration, learners develop the skills to express personal ideas, understand visual culture, and engage thoughtfully with art from a wide range of social, cultural, and historical perspectives. The program encourages experimentation, reflection, and collaboration, allowing students to grow as independent and confident visual thinkers.
Summary of Content
Students will explore a variety of artistic processes including lino printing, process drawing, mixed media weaving, and acrylic painting.
All learning is demonstration and process-based, emphasizing exploration, technique development, and creative problem-solving through both individual and collaborative projects.



Biology
Biology is the study of living things — how they function, grow, and interact with their environment. It helps us understand the incredible diversity of life on Earth, from the smallest microorganisms to the most complex human systems. In the Transition Year Biology module, students explore key areas of the subject in a practical and engaging way, developing both scientific knowledge and essential investigative skills in preparation for Senior Cycle Biology
Throughout the module, students study the human skeleton, learning about bones, joints, and how the body supports movement and protection. They also explore microbiology, where they discover the world of bacteria and fungi, gaining insight into both their beneficial and harmful roles. The senses are another exciting topic — students examine how humans perceive the world and take part in hands-on dissections to better understand biological structures such as the eye in real life. In the plant biology section, they learn about plant structure and growth while the study of DNA introduces them to the basis of inheritance and modern genetic science.
By completing the TY Biology module, students develop valuable skills such as scientific observation, data recording, critical thinking, teamwork, and practical laboratory techniques. They also enhance their ability to question, investigate, and communicate scientific ideas clearly. Overall, this module provides an enjoyable and enriching experience that deepens students’ appreciation of living systems and prepares them for further study in the sciences.
(A)
(B)
(A) TY’s learned about the skeleton by creating a model of it with cotton buds (B) TY’s swabbed various areas in the school and investigated the bacteria grown on nutrient agar dishes
Design & Communication Graphics (DCG)
In this exciting TY DCG module, students bring everyday products to life through design and 3D modelling. Each student selects a real-world object — a Bluetooth speaker, games controller, or hair straightener, for example — and begins by hand-sketching the object and its key features. They then recreate the object digitally using SolidWorks, a 3D parametric modelling programme, building it as a multi-part assembly just like professional designers do. Finally, students will scale down their models and prepare them for 3D printing, transforming their digital designs into tangible miniature models that can be taken home as keepsakes and a reminder of the process they undertook. This hands-on project blends creativity, technology, and problem-solving — giving students a real taste DCG (Design & Communication Graphics) which houses modern product design and engineering principles for real world application.
Business
Overview:
Transition Year (TY) Business is designed to bridge the gap between the Junior Cycle and Leaving Certificate, providing students with a comprehensive understanding of various business concepts and practices. Throughout the module, students will explore key areas such as personal finance and budgeting, entrepreneurship and innovation, marketing and branding, finance and the economy. Learning is hands-on and project-based throughout the year. This practical and engaging programme gives students an insight into the world of business, enterprise, and economics. It focuses on developing creativity, teamwork, problem-solving, and entrepreneurial skills through hands-on activities and real-world learning experiences.
Aims:
- To help students understand how businesses operate in society.
- To encourage innovation and enterprise through mini-company projects and competitions.
- To develop key business skills such as communication, planning, marketing, and financial management.
- To prepare students for Leaving Certificate Business, Accounting, or Economics, and for future careers in business.
Skills Developed:
- Teamwork and leadership
- Financial literacy and budgeting
- Critical thinking and decision making
- Presentation and communication
- Creativity and innovation
Assessment:
Students are usually assessed through projects, presentations, portfolios, and their involvement in business activities rather than traditional exams.
Cake icing TY
Our Transition Year students take part in a delightful 6-week Cake Icing & Decorating module that blends creativity with hands-on learning. Throughout the course, students explore a variety of fondant icing techniques, gaining skills in shaping, colouring, and decorating that bring their sweet creations to life.
Each week focuses on a seasonal or celebratory theme:
- 🎃 Module 1 – Halloween: Spooky fun with pumpkins, ghosts, and cobwebs
- 🎄 Module 2 – Christmas: Festive toppers like snowflakes, Santa hats, and holly
- 💘 Module 3 – Valentine's Day: Hearts, roses, and love-themed designs
- 🐣 Module 4 – Easter: Bunnies, eggs, and springtime motifs
- 🎓 Module 5 – Graduation/Summer: Sunshine, beach vibes, and celebratory caps
By the end of the module, each student has crafted six unique cupcake toppers which they proudly place on cupcakes and present in a beautifully decorated box—if they haven’t eaten them first!
This module is a fantastic opportunity for students to express their creativity, develop fine motor skills, and take home a delicious reminder of their hard work.

Chemistry
Our TY Chemistry module gives students a hands-on introduction to the world of chemistry through fun, practical activities and real-life investigations. Over eight weeks, students explore topics such as forensics, nutrition, product chemistry and environmental science, while learning key lab skills and safety.
From making bath bombs to testing vitamin C in juices and analysing water hardness, students discover how chemistry connects to everyday life, sustainability and industry. The module also develops teamwork, creativity and digital literacy through group projects, quizzes and presentations.
This taster helps students see how chemistry links with subjects like Biology, Geography and Business, while offering insight into careers in science and technology. It’s an exciting opportunity to experience chemistry in action and understand its impact on the world around us.
Coding
This year-long Scratch Coding Program gives Transition Year students a hands-on introduction to the world of coding. Using Scratch, a fun and easy-to-use visual programming platform, students learn how to think like a programmer while creating their own games, animations, and interactive stories.
Throughout the year, students will explore how computers follow instructions, how to break problems into smaller steps, and how to bring creative ideas to life through code. By the end of the year, students will have a solid understanding of basic coding concepts.
Cooking Module: Cooking for Independence
This engaging and practical module introduces students to essential cooking skills that will serve them well when living independently. Throughout the course, students will learn to prepare a variety of delicious and easy-to-make dishes, including homemade pizzas, flavourful spice bags, and a range of pasta meals.
A strong emphasis is placed on health, safety, and good kitchen hygiene at every stage of the learning process. Students will gain confidence in meal preparation, understand the importance of balanced nutrition, and develop valuable life skills that promote independence and healthy living.



English
The Transition Year English programme gives students the chance to develop their creativity, critical thinking, and appreciation of language and literature. Through reading, writing, and discussion, students engage with a wide range of texts, explore film and media, and express themselves through both creative and reflective writing.
The programme supports students’ intellectual, social, and emotional growth by encouraging a love of reading, an awareness of cultural identity, and the confidence to communicate effectively in different contexts. It also prepares students for the responsibilities and challenges of senior cycle and adult life.
Specific aims include:
- Developing critical literacy to navigate diverse linguistic and cultural contexts.
- Promoting an appreciation for literature in all its forms.
- Building competence in both oral and written communication.
- Encouraging independent learning and effective teamwork.
Finance
This 6-week course introduces students to the world of finance and investing, while also raising awareness about financial fraud and scams. Students will learn how the stock market works, what drives stock prices, and how investors make decisions.
Using an online simulation platform, students will choose and track their own stocks over the six weeks, gaining hands-on experience of how markets move,
Alongside this, the module highlights the importance of staying safe with money — covering real-world issues such as money muling, text message scams, and other forms of financial fraud. Students will explore how and why these scams happen, the warning signs to look out for, and how to protect themselves and others.
Future Leaders
What is Future Leaders?
The “Future Leaders Transition Year Programme” is a joint initiative from the GAA and Oide, the support service for teachers and school leaders. It is a cross-curricular programme comprising of a series of modules designed to encourage maturity, initiative, responsibility and leadership skills in pupils. The Programme gives pupils the knowledge and skills to support all roles required in the effective staging of Gaelic Games. As part of the Programme students are challenged to organise and run both on-field and off-field events for younger students.
What do future leaders do in Scoil Pól?
The future leaders in Scoil Pól have two classes per week. In these classes students will work towards completing several modules set out by the Future Leaders programme. Some of these modules include a referee course, coaching, sports journalism and event management. These modules will then be put into practice by the students as they will organise several events over the year such as the 6th class blitz and a 1st year sports day. Another key role which future leaders will carry out throughout the year is helping with the sports teams in Scoil Pól. Each future leader is assigned a team where they are responsible for helping the coaches prepare the necessary gear and organise the warm-up. Another key role during these matches is gathering statistics from the game and also updating the Scoil Pól social media. Make sure to keep an eye out for all the great work our future leaders are up to on instagram. @scoil_pol_kilfinane and @scoilpol_futureleaders.
Gaisce
Gaisce, or The President's Award, is Ireland's national youth award and a personal development program for people aged 14–25. Participants challenge themselves to achieve a personal goal over a set period by completing activities in four areas: Personal Skill, Physical Recreation, Community Involvement, and an Adventure Journey. There are three award levels: Bronze, Silver, and Gold, each with different time commitments.
Geography
In Transition Year Geography, students look at the world around them. The module runs on rotation, giving all students the opportunity to experience it and gain a real feel for the subject.
We begin by studying natural disasters such as volcanoes, earthquakes, and tsunamis, learning how these forces shape our planet and affect communities worldwide. Each rotation also focuses on a key local environmental campaign — from testing nitrogen levels in the air to examining traffic congestion in our local area. Students investigate these issues and design an action plan based on their findings, suggesting practical steps to improve our surroundings.
The module is fun, interactive, and hands-on, often taking learning beyond the classroom. Whether students are setting up air quality testers, collecting data outdoors, or creating posters to raise awareness, they are actively involved in discovering how geography connects to real life. Throughout the course, students develop important skills such as teamwork, research, mapping, data analysis, communication, and critical thinking — all of which provide an excellent foundation for Leaving Certificate Geography and for understanding global issues in a local context.
As part of our commitment to sustainability, students work together to make our school a more environmentally friendly and sustainable place. We are proud to collaborate with GLOBE Ireland, taking part in many of their exciting initiatives that encourage active learning and environmental awareness.

Hiking Module
As part of our Transition Year programme, students take part in a six-week hiking module, expertly guided by Britton Outdoors.
Mark Britton brings a deep passion for nature and adventure, inspiring our TY students to embrace the outdoors. The hikes take place in the breathtaking Galty Mountains and Ballyhoura’s.
This module includes a Mountain Navigation component, where students develop essential map reading and navigation skills. The goal is to empower them to explore local trails safely, confidently, and independently — skills they can carry with them for life.
History
What is TY History?
TY History builds on the interest and enthusiasm for History acquired at Junior Cycle. It is a course designed to help students explore the past in a more engaging and hands-on way than in the Junior Cycle. It encourages curiosity, independent thinking, and critical analysis of historical events, people, and ideas. TY History class encourages debate, discussion and the development of personal views. Rather than focusing solely on exams, students get the chance to investigate local history, complete projects, visit historical sites, and use different sources such as photographs, newspapers, and oral histories. The aim is to develop research, communication, and analytical skills while deepening students’ understanding of how the past has shaped the world today. Transition Year History often connects with other subjects and current issues, helping students see the relevance of history in modern society.
Some of the modules studied include:
Irish Women’s Campaign for the Right to Vote 1870-191
- The changing role of Women in the 19th & 20th Century
- The origins of the Campaign for Irishwomen’s Suffrage
- The Irish Women’s Franchise League and the power of Propaganda
- The Campaign for the Vote on the eve of the First World War
- The establishment of Cumann na mBan
- An Introduction to American History 1945-1989:
- Racial Conflict
- Rosa Parks
- Martin Luther King
- The Montgomery Bus Boycott
- 1969 Moon Landings
- The Vietnam War
An Introduction to European History - World War I
- Irish involvement in WWI
- Battle of the Somme, using documentary evidence
- Advances in technology
- New styles of warfare
- Effect on civilian populations
Home Economics
Transition Year Home Economics is a subject that runs for the full academic year. It is very practical focused with students developing their skills by making a variety of sweet and savoury dishes throughout the year. We cover a variety of topics such as ethnic cooking by exploring different culinary dishes from around the world, learning new textile skills by making seasonal crafts and focusing on specific culinary disciplines such as pastry. This subject allows students to continue the development of life skills that they obtained in junior cycle, while also expressing their personalities and preferences through their presentation of dishes and choice of craft design. There is also an opportunity for students to get a taste of elements of Leaving Certificate Home Economics with exposure to sensory analysis and components of the Leaving Certificate Coursework. The skills and knowledge obtained from this subject can be of great benefit to any student studying Home Economics for senior cycle but more importantly for life beyond school.


Irish
In Transition Year, our students explore the wide range of career opportunities available through the Irish language. This term, they have been focusing on Irish-language media, trialling real-world roles such as interviewing people , presenting the news, and delivering the weather forecast using a green screen and the iMovie app. They are also developing digital skills by creating podcasts and designing promotional posters on Canva. As part of their TY experience, students research college courses linked to these media pathways and explore further career options in areas such as education, European institutions, communications, marketing, and Irish language organisations such as Gael Linn. Alongside this, students study Irish place names, culture, and folklore, gaining a richer understanding of the heritage that shapes these employment opportunities.
Junk Kouture Module
In this creative, year-long module, students take part in the exciting Junk Kouture competition a national event that blends fashion, design, and sustainability. Throughout the year, students work individually or in teams to design, collect materials, and craft a one-of-a-kind outfit made entirely from recycled and repurposed items.
The module promotes creativity, collaboration, and environmental responsibility, encouraging students to think sustainably and showcase their artistic talents. The experience culminates in students presenting and modelling their creations as part of the Junk Kouture competition, representing the school with pride and innovation.


Life Skills
Ever wondered how to change a tyre, budget for your first apartment, or iron a shirt without burning it? Welcome to Life Skills, the TY class that gets you ready for the real world!
In this hands-on, laugh-out-loud, learn-by-doing course, you’ll discover the practical (and surprisingly fun!) side of adulting. From health and beauty hacks to home finance basics, from job interviews and first impressions to mastering the art of small talk — you’ll walk away with confidence, independence, and a toolkit for life.
Get ready to:
🚗 Learn basic motor maintenance (yes, you’ll know what’s under the bonnet!)
🏠 Explore the cost of moving out and managing your own home
💰 Handle budgets, bills, and basic accounts like a pro
💅 Discover your personal style and professional polish
👔 Iron a shirt, tie a tie, and ace your next interview
💬 Build confidence, conversation skills, and a can-do attitude
Life Skills is about learning what really matters — and having a great time doing it. Because being ready for life doesn’t have to be boring!
Mathematics
In Transition Year, Mathematics offers students a valuable opportunity to explore the subject beyond the constraints of the syllabus. The focus is on developing problem-solving abilities, logical thinking, and mathematical confidence through real-life applications and project-based learning. Students engage in activities such as statistics projects, budgeting exercises, and puzzles that strengthen their analytical and numeracy skills. Collaborative work and independent exploration help them understand how maths connects to science, technology, and everyday decision-making. This year allows students to build a deeper appreciation for mathematics while preparing them with the critical thinking and reasoning skills needed for the Leaving Certificate and beyond.
Students also get the opportunity to discover the importance of mathematics in a wide range of future careers. Through project work and career research, students have a chance to see how mathematics is used in fields such as engineering, architecture, business, finance, computer science, and healthcare. Overall, the transition year mathematics module gives students a clearer sense of how maths can shape their future studies and professional choices.


Mini Company
Transition Year Mini Company provides all students with the opportunity to set up their own company within the school. The module allows students to be innovative and creative while studying entrepreneurship.
All students take part in a Shark Tank activity before the October midterm which allows them to share their ideas with the rest of the class, along with a prototype of what they will sell. This activity is usually the most exciting one as the room fills with creative ideas.
This provides the opportunity to be supportive of each other and give feedback based on their knowledge of what entrepreneurship is. All students take this feedback and fill out a reflection in their TY portfolios which informs their preparation for the Christmas market.
We have had many successful companies over the years, with some students even continuing to sell their products long after the market has ended. From Scoil Pól merchandise, to handmade Christmas decorations to Late Late Toy Show boxes, the creativity in TY Mini Company never disappoints year on year.

Modern Foreign Languages: Spanish and French
Our Transition Year Modern Foreign Languages (MFL) programme offers students the opportunity to deepen their knowledge of Spanish or French while developing essential skills for life beyond the classroom. The programme focuses not only on language learning but also on personal, cultural, and career-related growth, helping students become confident global citizens.
Through a range of creative tasks, project-based learning, and the use of digital tools, students explore language in authentic and engaging ways. Activities include producing multimedia projects, collaborative research, and interactive presentations, all designed to enhance communication, creativity, and teamwork.
A key part of the TY MFL experience is the emphasis on oral communication, helping students build confidence in speaking and preparing them for the Leaving Certificate oral examinations. Regular conversation practice and interactive speaking tasks (often with native speakers) allow students to express themselves naturally and fluently in real-world contexts.
We also explore cinema as a window into language and culture. By studying films from Spain and France, students gain insights into contemporary society, social themes, and everyday language use bringing language learning to life and deepening cultural awareness.
Some of our TY students also take part in the Erasmus+ exchange programme, spending time in partner schools in Spain and France. This unique opportunity allows them to immerse themselves in the language and culture, build lasting international friendships, and experience first-hand what it means to live and learn in another country.
Overall, the TY MFL programme aims to inspire curiosity, independence, and confidence preparing students not only for the Leaving Certificate but also for future study, travel, and careers in an increasingly interconnected world.
Music
Transition Year Music gives students the chance to experience music in a creative, hands-on, and enjoyable way. The year begins with a look at the history of rock and pop, including a study of Queen’s Bohemian Rhapsody. Students work together on research projects, performances, and presentations, while also preparing for the much-anticipated School Musical, a highlight of the school year that showcases students growing confidence and talent.
As the year progresses, students develop their musical skills further through composition and harmony. They learn how to write their own melodies, explore chord progressions, and have an introduction to elements of Leaving Certificate Music. Group performances and practical tasks help them to apply what they’ve learned while building teamwork and creativity.
In the final term, students explore the world of Romantic music, discovering composers like Tchaikovsky and the dramatic sounds of Romeo and Juliet. They explore this era in depth through listening, performance, and research. Throughout the year, every student is supported to reach their potential, with a focus on collaboration and developing an appreciation for music
Musical
At Scoil Pól, the Transition Year Musical Module is one of the most exciting and memorable parts of the TY programme. Over the years, our students have wowed audiences with fantastic productions such as Back to the 80s, Footloose, and High School Musical.
Throughout the module, students work together over several months to bring their performance to life - developing valuable skills in music, drama, stagecraft, choreography, and production. Whether performing under the spotlight or contributing behind the scenes, every student plays an important part in making the show a success.
Some students shine on stage through acting, singing, and dancing, while others take charge of set design, costumes, lighting, and backstage management. This collaborative experience helps students build confidence, enhance communication skills, and develop creativity - all while having great fun along the way.
The module culminates in a live performance for family and friends, where students showcase their hard work and talent to a delighted audience. It’s always a night to remember - and a true highlight of the TY year at Scoil Pól.

MY-Psy: Promoting Positive Mental Health through Psychology
What is MY-Psy?
MY-Psy (MY-Psychology) is a youth-centred psychology programme designed to promote positive mental health and wellbeing among Transition Year (TY) students. This innovative, research-based module was developed collaboratively with teachers, young people, and key stakeholders to support the Junior Cycle Wellbeing curriculum and to promote wellbeing through psychological science.
Developed in partnership with the Limerick & Clare Education & Training Board (LCETB), the HSE, the Junior Health Sciences Academy (JHSA, UL), Jigsaw, and the MY-Psy Youth Advisory Panel, MY-Psy offers students a unique opportunity to explore psychology in a meaningful and engaging way.
Programme Context
Youth mental health is one of the most important health issues facing young people today. Research and policy both highlight the need to promote positive mental health and wellbeing within schools, encouraging students to develop resilience and protective behaviours.
MY-Psy aims to help students understand mental health from a psychological perspective — exploring how different factors influence our thoughts, emotions, and behaviours. Through interactive, evidence-based learning, students gain insights into how psychology can be used to support wellbeing and positive change in everyday life.
MY-Psy Modules
The MY-Psy programme includes a range of engaging modules such as:
- Managing Social Media
- Building Positive Relationships
- Understanding Emotions
- Changing Our Health Behaviour
Each module is taught through a psychological lens, using active learning techniques that encourage discussion, reflection, and real-world application.
Why MY-Psy?
MY-Psy offers an introduction to the world of psychology — giving young people a taster of psychological science beyond the laboratory. It helps students see how psychology applies to their own lives and communities, inspiring curiosity about human behaviour, wellbeing, and the science of the mind.
Overall, MY-Psy is an exciting and accessible way for students to develop science literacy, enhance self-awareness, and build positive wellbeing skills that will benefit them far beyond the classroom.
Physics
Transition Year Physics in Scoil Pól is an engaging and hands-on introduction to the Leaving Certificate programme. The course focuses on exploring the principles of Physics through practical experiments, projects, and real-life applications rather than formal exams. Students get the opportunity to investigate topics such as forces, energy, light, and density while developing problem-solving and critical-thinking skills. The aim is to make physics enjoyable and relevant, encouraging curiosity and an appreciation for how physics shapes the modern world.

SPHE – Discover Yourself, Build Confidence, Live Well!
TY SPHE is all about you — who you are, how you connect with others, and how to live a healthy, happy, and balanced life. This is your chance to hit pause, reflect, and grow in ways that go far beyond the classroom.
Through fun discussions, creative projects, and real-life activities, you’ll explore everything from mental health and wellbeing to friendships, relationships, personal values, and self-confidence. You’ll learn how to manage stress, make good decisions, and build positive habits that will last long after TY.
Get ready to:
🧠 Boost your emotional intelligence and resilience
💬 Strengthen communication and teamwork skills
💖 Explore identity, empathy, and respect in relationships
🏃♀️ Discover the power of self-care and healthy living
🌍 Build awareness of the world around you and your role in it
SPHE in Transition Year is about growing into your best self — confident, connected, and ready to take on whatever comes next.
Because understanding yourself is the first step to shaping your future.
Swimming Module
As part of our transition year programme Students take part in a six to eight week swimming block in the University of Limerick sports arena. The swim program is led by Snamh Linn. Each student gets then opportunity to either learn how to swim, improve their technique or have the opportunity to become lifeguards or assistant swim teachers. It is an excellent run programme in which students like to attend every week.
Religion
As a Catholic school, Religious Education plays an important part in the life and work of Scoil Pól. Transition year students follow the Look Up! Programme which includes but is not limited to topics such as social justice, spirituality and moral decision making. This Religious Education programme encourages students to reflect and be active Christians in our world. Students are also given the opportunity to engage in different fundraising and charitable activities. All Transition year students have an opportunity to engage in liturgical activities throughout the academic school year.


Road Safety
Road Safety Matters is a road safety programme aimed at TY students to help them develop the knowledge, skills, values and dispositions to become safe road users. It is a simple step-by-step guide in preparing, educating and supporting students as safe road users. It aims to enrich students’ understanding of how our roads are shared spaces and how we can prepare and practise to ensure we are all safe road users.
The module is designed in a concise, easy-to-follow, and engaging format. It is a continuation and progression of prior road safety learning.
Students will look at various units throughout the module: Setting the scene, Learning to drive, Components of a car, Speed, Alcohol, Drugs, Distractions, Seat Belts and Vulnerable Road Users.
TY students in Scoil Pól have one class of Road safety per week. In this class, students get a chance to learn the rules of the road, understand what being a safe road user is and experience various activities and iniatives associated with road safety. All students have been given a student logbook where they can record information and track their learning. This book can be used as a study tool when these students get ready to sit the driving theory test. Once all students have completed the module, we will try organise for the RSA simulation road truck to come out to Scoil Pól. These roadshows bring road safety education to life in an engaging, interactive, and memorable way. It is a terrific opportunity for students to develop their own personal growth and set them up for their future as safe and responsible drivers, passengers, pedestrians, etc. on the road.
The attached photos are of students using drunk and drug goggles to experience the effect of trying to complete simple activities under the influence.

Woodwork
During Transition Year in Scoil Pol the TY students are encouraged to further their skills from Junior Cycle Wood Technology. All students have completed three years of Junior Cycle Wood Technology so have experienced the basics of wood-working skills and hand-crafted joints. The first project we generally start with is a wall-mounted key holder that incorporates a hand-crafted bridle joint and the processing of a mortise using only hand tools. This mortise allows a 6mm plywood personalised design created on the laser machine to fit into the project.
Once the first project has been completed we then encourage students to pick personalised wood crafted projects that will expose them to new skills that they can carry forward into Senior Cycle Construction Studies. These skills can range from use of power tools under teacher supervision, wood-turning on the lathe, CNC router activities, etc.
The year is spent completing practical tasks and a hands-on approach to Woodworking to help build on students past skills and expose them to new techniques and processes to continue the high standard of project-work within our school department.
YSI
Students have the opportunity to participate in the Young Social Innovators Programme (YSI) during Transition Year. Students are supported to create team-based action-projects on issues that they care about. While students put their innovative ideas into action they will bring about positive social change for the benefit of people, communities and the environment.
Scoil Pól has been recognised as a centre of excellence for YSI as a result of the completion of high standard projects. Scoil Pól projects have also been successful in achieving awards within the programme. Previous projects that we have seen in Scoil Pól have included: Animal Welfare, Sports, Mental Health, Homelessness, Fire Safety, Equality, Breast Cancer, Water and Sun Safety, Drug Abuse, Equality in Sport, Healthy Eating Habits, Teenage Addictions and Vaping.
The aim of this module is to provide an education on social innovation that empowers young people to act on social issues and for students to feel inspired, empowered and equipped to bring about positive change. Each class group will work as a team to develop a project throughout the year which will allow students to mature socially. Throughout this module, students make a positive contribution to the school and wider community whilst raising awareness on their selected topic.